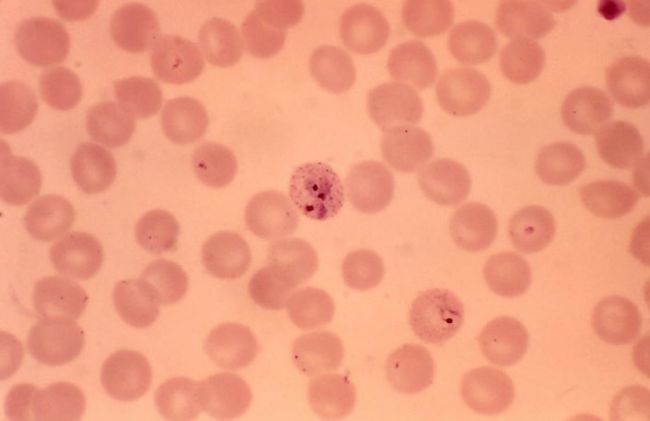
globulos-rojos-palidos

Ya estamos atendiendo nuevamente comuniquese con nosotros por whatsapp al +51 - 973586834 para recibir nuestros tratamientos.
Conoce las propiedades de la spirulina para la anemia y recupera tu energía, apetito y buen ánimo.
Aprende la cantidad de hierro y su disponibilidad en la espirulina, los beneficios de su contenido en hierro, la comparación con el hierro de otros alimentos y suplementos para incrementar el hierro en el cuerpo.
Descubre cómo elegir y comprar una espirulina de buena calidad y cómo emplearla para combatir tu anemia, un problema de alta prevalencia en nuestra sociedad.

El alga spirulina, científicamente conocida como “Arthrospira Platensis” pertenece a un grupo de algas llamadas verde-azules, que adquieren ese color debido a la exposición al sol y la presencia de clorofila y se encuentran naturalmente en lagos y océanos, lo que las nutre de vitaminas y minerales.
Las condiciones de salinidad y ph alcalino de las aguas en las que se encuentran afirman su seguridad como suplemento alimenticio.

Solo 10 gramos de algas contienen 10 mg de hierro, es decir el 55% de la recomendación diaria de hierro.
A su vez, según un estudio realizado en Antenna Foundation, la spirulina es rica en vitamina A, que facilita la absorción del hierro. De 1 a 2 gr de spirulina contienen la cantidad de vitamina A recomendada al día, comparable a fuentes como zanahoria o vegetales de hoja. (1)
Puedes agregar la spirulina solo en un vaso con agua, ahora si te gustaria combinarla con frutas y verduras en deliciosos jugos, te invito a aprender como hacerlo en nuestro Libro de Desayunos Verdes. Haz clic para conocer nuestro Libro: Ver el Libro de Desayunos Verdes

De acuerdo a un estudio realizado en Ronore Enterprises, mujeres que se encontraban limitando las calorías de su dieta para mantenerse delgadas, presentaron anemia comprobada por una disminución de la hemoglobina.
Por otro lado, un grupo de atletas que presentaba un déficit de hierro, luego de incorporar la spirulina durante dos meses, mostraron un aumento significativo de sus reservas de hierro además de mejorar su rendimiento.
En los juegos olímpicos los deportistas de China y Cuba utilizan botellas de agua con spirulina para prevenir la anemia, lo cual además les permite mejorar la recuperación física y optimizar su sistema inmune.
Durante el embarazo, en la India y Vietnam las mujeres consumen la spirulina para evitar la anemia, debido a que es rápidamente digerible la proteína y contiene hierro altamente absorbible y sin grasas a diferencia de las carnes.
Las madres ofrecen también las algas a sus niños, ya que es una excelente fuente de hierro y sin efectos secundarios apta para personas de todas las edades.
Además el 73% de la spirulina es consumida por mujeres mayores de 50 años, quienes las eligen por ser fácilmente digerible y absorbible, lo cual previene la anemia y reemplaza el hierro de la carne. (2)

La spirulina contiene 10 veces más de hierro que los alimentos comunes. Entre los 16 alimentos fuentes de hierro, la spirulina ocupa el primer puesto, seguida por el alga chlorella. En el punto 9 recién ubicamos a la carne vacuna.
Según un estudio realizado en Antenna Foundation, contrastado con los suplementos comerciales, como el sulfato de hierro, el hierro de la spirulina se absorbe un 60% más y sin efectos secundarios como los que produce el sulfato como toxicidad y diarrea.
Si comparamos el hierro de la spirulina con los granos enteros estos contienen entre 150-250 mg/ kg pero tienen sustancias que pueden limitar la absorción del hierro, la spirulina no tiene componentes inhibidores y además contiene 580-1800 mg / kg.
La evidencia científica confirma que el alga spirulina constituye el mejor suplemento natural de hierro para prevenir la anemia. (1)

De acuerdo a un estudio realizado en University of California, a la hora de elegir tus algas spirulina debes tener en cuenta la calidad del aire y agua de la cual se obtuvieron o cultivaron.
Para evitar esto, asegúrate que las algas que adquieras en tu tienda natural se encuentren verificada por un organismo que asegure su calidad como la FDA, además comprobar que esté libre de GMO (organismos modificados genéticamente) y sean 100% natural.
Siempre recuerda conservar la spirulina en frío en el refrigerador entre 3 a 5°, debido a que se trata de un producto fresco de origen vegetal. (3)

Es posible consumir la spirulina en cualquier momento del día, en algunas personas puede producir un aumento de energía, por lo cual intenta no incorporarla cerca de la hora de dormir.
En batidos puedes mezclar una cucharada de spirulina con naranja natural, papaya y frutillas. Recuerda que la vitamina C de las frutas, especialmente presente en cítricos y frutilla y kiwi mejora la absorción del hierro.
Del mismo modo, prueba licuados verdes, batiendo hojas de espinaca, limón, kiwi, ricos en vitamina C, banana, manzana verde, hojas de menta con 1 cucharada de spirulina.
Elabora bocaditos procesando la spirulina con dátiles, nueces, semillas y espolvoreando con coco en copos.
Entre 3 y 5 gr diarios, lo cual equivale a una cucharadita de café y té respectivamente resultan suficientes para aprovechar los beneficios de la spirulina.
De acuerdo a un estudio realizado en University of California, 3 gr de spirulina durante 2 semanas, especialmente en mujeres que presentaban anemia, aumento la hemoglobina en sangre, controlando su anemia.
La spirulina es útil en todas las etapas de la vida, es versátil y aceptable para su consumo en variedad de platos salados y dulces.
De acuerdo a un estudio realizado en Université Montpellier II, la anemia afecta al 20% de la población mundial. Especialmente la anemia se produce en mujeres, niños y adultos mayores.
Un aporte adecuado de hierro en nuestra dieta es importante para la formación de los glóbulos rojos y células musculares, para obtener oxígeno y energía y para el mantenimiento del sistema inmunológico.
Según un estudio elaborado en Hind Institute of Medical Sciences, la spirulina ha sido empleada por astronautas y la NASA declaró que el valor nutricional de 1000 kg de frutas y verduras equivale a un 1 kg de espirulina. (4) (2) (5) (6)
Conociendo el amplio valor nutricional de las frutas y verduras, no dejemos de probar la spirulina y obtener sus beneficios para combatir la anemia. La spirulina es un suplemento natural para refozar tu hierro.
En nuestro Libro de Desayunos Verdes encuentra recetas para agregar la spirulina, aprende cuales son las porciones adecuadas de uso y como aprovecharla al maximo. Conoce nuestro libro de Desayunos Verdes en el siguiente link: Descubrir el Libro de Desayunos Verdes